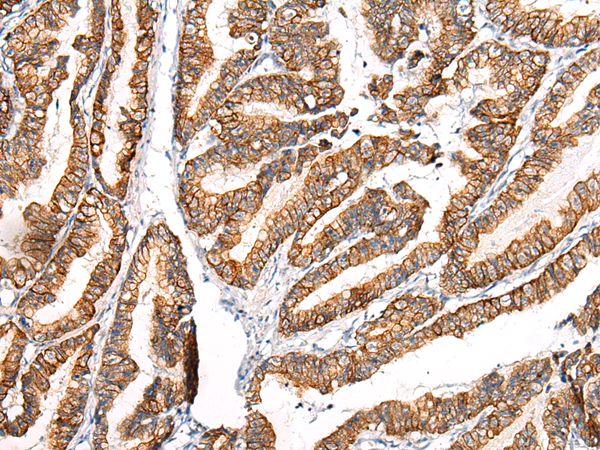
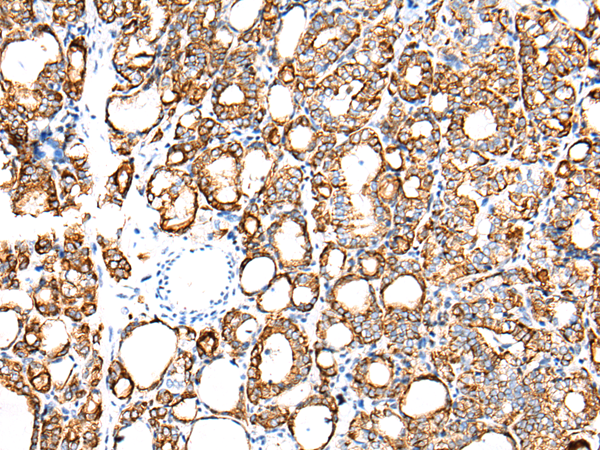
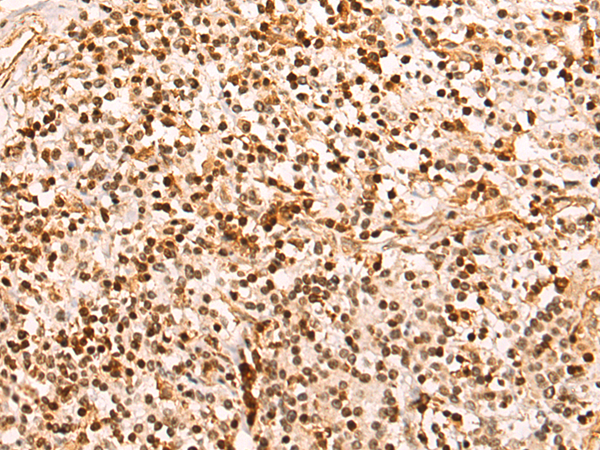

-
分类: 科研抗体货号: P12455别名: MG2应用: IHC反应种属: Human
-
分类: 科研抗体货号: P12454别名: FECD; PPCD; FECD1; PPCD2应用: IHC反应种属: Human, Mouse
-
分类: 科研抗体货号: P12470别名: MRP; ABCC; GS-X; MRP1; ABC29应用: WB,IHC反应种属: Human
-
分类: 科研抗体货号: P12452别名: K7; CK7; SCL; K2C7应用: WB,IHC反应种属: Human
-
分类: 科研抗体货号: P12487别名: CX31.1应用: IHC反应种属: Human, Mouse, Rat
-
分类: 科研抗体货号: P12469别名:应用:反应种属: Escherichia coli
-
分类: 科研抗体货号: P12451别名: APEL; XNPEP2应用: IHC反应种属: Human, Mouse, Rat
-
分类: 科研抗体货号: P12486别名: CDX3; CDX-3; CDX2/AS应用: WB,IHC反应种属: Human, Mouse
-
分类: 科研抗体货号: P12468别名:应用: IHC反应种属: Human, Mouse, Rat
-
分类: 科研抗体货号: P12450别名: ADTAA; CLAPA1; AP2-ALPHA应用: WB,IHC反应种属: Human, Mouse

鄂公网安备42018502007531号
鄂公网安备42018502007531号

